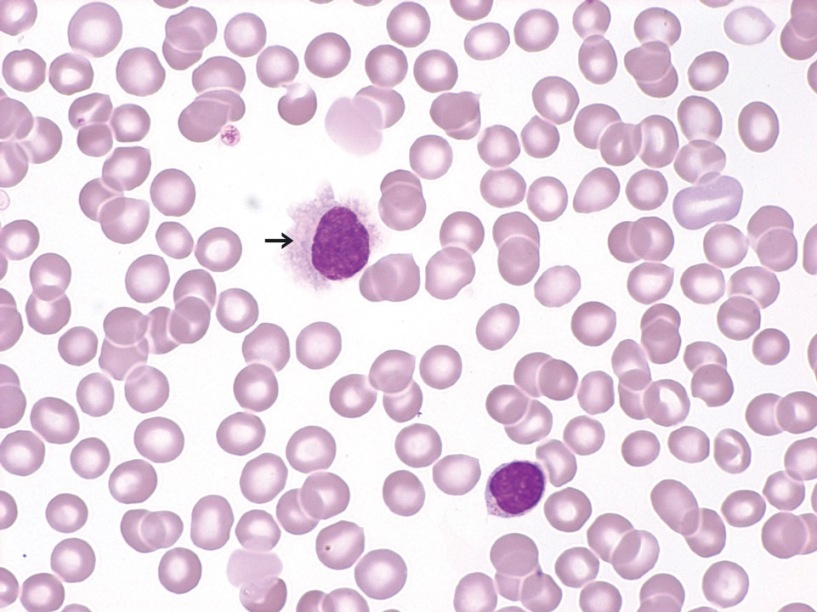
Аномальные клетки лимфы под микроскопом Аномальные клетки лимфы под микроскопом

Особенности волосатоклеточного лейкоза и чем он опасен
Эта болезнь является одной из форм хронического лейкоза, проявляющегося разрастанием лейкоцитов. Данная доброкачественная патология выделяется из общей группы лейкозных заболеваний из-за специфичной морфологии. Волосатоклеточный лейкоз (ВКЛ) диагностируется редко — около 7 случаев на один млн. человек в год. Средний возраст заболевших таким видом рака — 50 лет.
Опасность волосатоклеточного лейкоза — в бессимптомном начальном этапе развития и последующем резком прогрессировании. Возникает нехватка клеток крови, которая приводит к гибели пациента, из-за анемических, геморрагических и инфекционных осложнений.
Врачи отмечают, что волосатоклеточный лейкоз является редким, но важным заболеванием, требующим внимательного подхода к диагностике и лечению. Специалисты подчеркивают, что раннее выявление болезни значительно улучшает прогноз для пациентов. Симптомы, такие как усталость, увеличение селезенки и лейкопения, могут быть не специфичными, что затрудняет диагностику на ранних стадиях. Врачи рекомендуют проводить регулярные обследования для людей с предрасположенностью к этому заболеванию. Лечение, как правило, включает химиотерапию, которая показывает высокую эффективность. Однако важно учитывать индивидуальные особенности каждого пациента, чтобы минимизировать побочные эффекты и повысить качество жизни. В целом, мнения врачей сходятся на том, что комплексный подход к лечению и поддерживающая терапия играют ключевую роль в успешной борьбе с волосатоклеточным лейкозом.

Причины и группы риска
Причины возникновения этой патологии точно не выявлены, но есть несколько предрасполагающих к возникновению этого заболевания факторов:
- регулярное употребление пищевых продуктов с канцерогенами;
- длительный контакт с вредными химическими веществами;
- воздействие радиации.
Также отмечено, что заболеванию волосатоклеточного лейкоза чаще подвержены мужчины, которые перешагнули 50-летний рубеж. Обнаружение рака у лиц пожилого возраста можно объяснить тем, что болезнь продолжительное время может развиваться незаметно, но со временем старение организма ускоряет проявление симптомов.
Механизм заболевания происходит так: в костном мозгу происходит сбой в процессе деления и дифференцировки. При нормальном развитии из базальной клетки образовываются два ростка — миелоидные и лимфоидные клетки. Миелоидные дают основу для формирования эритроцитов, лейкоцитов и тромбоцитов. Из лимфоидной должны созревать В-лимфоциты, Т-лимфоциты и, так называемые, натуральные киллеры (эти клетки в дальнейшем уничтожают опухолевые клетки и вирусы). Процесс созревания нарушается и лимфоидные клетки не созревают. Аномальные разрастающиеся клетки лейкоцитов накапливаются в костном мозге и начинают вытеснять из него нормальные клетки — тромбоциты, лейкоциты, эритроциты. Незрелые лимфоциты мешают работе других составных частей крови и сами не выполняют своих функций по защите крови.
Симптомы волосатоклеточного рака
Волосатоклеточный лейкоз нарушает весь процесс кроветворения и вся симптоматика связана именно с этим.
Увеличение количества измененных лейкоцитов способствует увеличению селезенки — развивается спленомегалия. Нарастающая спленомегалия проявляется тяжестью в правом боку, пальпация помогает обнаружить эластичную часть селезенки.
Кроме этого симптома можно наблюдать и ряд других:
- геморрагический синдром. При его возникновении могут наблюдаться частые и беспричинные кровотечения. Могут быть кровотечения из носа, наблюдаться кровоточивость десен, у женщин — маточные кровотечения;
- анемический синдром. Внешне проявляется ломкостью волос, бледностью и желтизной кожи, утомляемостью, похолоданием конечностей, по анализам крови — снижением эритроцитов;
- иммунодефицитный синдром. Характерен частым повторением инфекционных и респираторных заболеваний.
Также волосатоклеточный лейкоз можно предположить и по таким признакам:
- регулярное возрастание температуры тела;
- болевым ощущениям сверху и слева в брюшной полости;
- возникновению на коже синяков, которые появляются даже при малейшем ушибе;
- учащенному дыханию, одышке, даже при незначительных нагрузках;
- резкому уменьшению веса, отсутствию аппетита;
- опуханию лимфатических узлов. Можно прощупать увеличенные шейные, паховые, подмышечные лимфоузлы, реже — лимфатические узлы живота.
Важно! По незнанию, часть из этих перечисленных симптомов пациенты относят к общему старению организма и поэтому обращение к врачу откладывается.
На более поздних стадиях волосатоклеточного лейкоза могут проявляться:
лимфаденопатия — рост лимфатических узлов;
- цитопения — нехватка кровяных клеток одного или нескольких видов;
- вторичные опухоли.
Часто это заболевание ассоциируется с узелковым периартериитом — антителами поражаются сосудистые стенки мелких артерий. Осложнениями этого вида рака может быть нейролейкоз, при котором метастатическими клетками поражаются мозговые оболочки, черепные нервы, нервные стволы и вещества мозга.
Волосатоклеточный лейкоз — это редкая форма хронического лейкоза, и мнения о нем среди пациентов и врачей могут сильно различаться. Многие пациенты отмечают, что диагноз стал для них шоком, так как заболевание часто проявляется бессимптомно на ранних стадиях. Однако, благодаря современным методам диагностики и лечения, многие люди чувствуют себя более уверенно. Врачи подчеркивают важность раннего выявления и регулярного наблюдения, так как это позволяет контролировать заболевание и улучшать качество жизни. Некоторые пациенты делятся положительным опытом, рассказывая о том, как эффективные методы терапии помогли им вернуться к привычной жизни. Тем не менее, существует и страх перед рецидивом, что делает поддержку со стороны близких и медицинских специалистов особенно важной. В целом, обсуждение волосатоклеточного лейкоза подчеркивает необходимость информированности и открытого диалога о заболевании.

Стадии
Для удобства выбора вида терапии выделяют четыре стадии этого заболевания:
- первоначальный лейкоз (нелеченная стадия) — характеризуется изменениям, которые обнаруживаются в костном мозге — по аномально измененным лимфоцитам. Иногда единственным симптомом бывает только увеличенная селезенка, которую можно пропальпировать при осмотре;
- прогрессирующаястадия — происходит развитие атипичных лимфоцитов, уменьшается количество тромбоцитов, эритроцитов и лейкоцитов. На этой стадии происходит метастазирование, поражаются чаще всего ткани сердца, головной мозг. Развивающаяся в отдаленном очаге опухоль состоит из лейкозных клеток;
- рецидивирующая стадия протекает, когда проведено лечение и допускается появление рецидивов заболевания.
- рефракторная стадия диагностируется, когда у пациента выявляют лейкоз, который уже нельзя вылечить.
Диагностика волосатоклеточного лейкоза
Диагностирование волосатоклеточного лейкоза проводится при помощи следующих методов обследования:
- личный осмотр врачом, анализ анамнеза заболевания;
- анализ крови, который показывает наличие атипичных лимфоцитов и уменьшение тромбоцитов, эритроцитов и лейкоцитов (панцитопения);
- цитохимия, которая применяется для исследования динамики химических процессов в клетках;
пункция костного мозга и его гистологическое исследование на наличие атипичных лимфоцитов;
- КТ, используется для диагностирования опухолей внутренних органов и увеличенных лимфатических узлов.
Кроме этого, требуется дифференцирование ВКЛ с другими заболеваниями, имеющими патологические клетки лимфоидной природы.
При личном осмотре врач может найти признаки, указывающие на волосатоклеточный лейкоз:
- при пальпации костей ощущается болезненность;
- увеличенная селезенка, печень;
- увеличенные безболезненные лимфоузлы.
В общем анализе крови на данный вид лейкоза указывают такие признаки:
- уменьшенный уровень гемоглобина;
- сниженное количество эритроцитов, тромбоцитов, лейкоцитов;
- повышенное количество лимфоцитов (незрелых);
- увеличение скорости оседания эритроцитов.
При пункции костного мозга (трепанобиопсии) выявляются характерные признаки заболевания:
- гиперплазия клеток костного мозга;
- разрастание миелоидного ростка кроветворения.

Лечение
При выборе метода лечения руководствуются следующими параметрами — стадией рака, количеством лейкозных клеток, выраженностью симптомов болезни.
Лечение волосатоклеточного лимфолейкоза начинается не сразу после постановки диагноза.
Сначала применяют выжидательную тактику, это значит, что до возникновения определенных признаков лечение не проводится:
- общее уменьшение клеток крови в общем анализе;
- часто возникающие инфекции;
- клинические проявления спленомегалии (например, признаки сдавления органов, находящихся рядом с селезенкой).
Если присутствует хотя бы один из перечисленных признаков прогноз для больного ухудшается. Поэтому терапию надо начинать сразу после возникновения данного состояния.
При сильно увеличенных размерах печени делают спленэктомию, чем добиваются нормализации состава крови (метод невысокой эффективности). Назначают химиотерапию для уничтожения раковых клеток и разрушения метастаз. Зачастую используют лекарственное средство «Кладрибин». Его применение способствует ремиссии в 80 % случаев.
Также хорошего результата можно добиться используя в качестве лекарства «Интерферон».

Кроме основного лечения пациентам подбирается медикаментозная терапия, а после полученного курса лечения надо постоянно проходить обследование, чтобы вовремя захватить рецидив заболевания.
Также рекомендуется соблюдение определенного режима питания — диеты, которая преследует своей целью:
- улучшение работы иммунной системы;
- борьбу с анемией;
- повышение аппетита.
С помощью полноценного и правильного питания предполагается снижение негативного воздействия химиотерапии и улучшения показателей крови.
Прогноз
Волосатоклеточный лейкоз отличается доброкачественным течением болезни. Он развивается медленно и отлично поддается своевременной терапии.
После 65 лет течение болезни усугубляет физическое старение организма. У этих больных симптомы заболевания нарастают стремительнее, а при хирургическом лечении и химиотерапии последствия тяжелее.
При адекватном лечении прогноз благоприятный — в 95% случаев выживаемость составляет более 10 лет. У пациентов после 70 лет выживаемость хорошая только в случае ранней диагностики заболевания. Если волосатоклеточный лейкоз не лечить, то средняя продолжительность жизни не превышает 5 лет. Причиной смертности в 25% случаев бывают именно осложнения.
Вопрос-ответ
Что характерно для волосатоклеточного лейкоза?
Волосатоклеточный лейкоз — это редкая разновидность хронического лимфопролиферативного заболевания, относящаяся к группе В-клеточных лейкозов. Характерной особенностью является появление в крови атипичных лимфоцитов с «волосатыми» отростками цитоплазмы, по виду напоминающими ворсинки.
Какой самый агрессивный лейкоз?
Острый тучноклеточный лейкоз является исключительно агрессивной формой острого миелоидного лейкоза и имеет очень плохой прогноз.
Советы
СОВЕТ №1
Обсуждайте свои симптомы и беспокойства с врачом. Если у вас есть подозрения на волосатоклеточный лейкоз или вы испытываете необычные симптомы, важно как можно скорее обратиться к специалисту для диагностики и получения рекомендаций по лечению.
СОВЕТ №2
Следите за своим состоянием и регулярно проходите обследования. При наличии диагноза волосатоклеточного лейкоза важно регулярно посещать врача для мониторинга состояния и корректировки лечения при необходимости.
СОВЕТ №3
Поддерживайте здоровый образ жизни. Правильное питание, регулярные физические нагрузки и отказ от вредных привычек могут помочь укрепить иммунную систему и улучшить общее состояние здоровья во время лечения.
СОВЕТ №4
Ищите поддержку среди близких и сообществ. Общение с людьми, которые сталкиваются с аналогичными проблемами, может оказать значительное эмоциональное воздействие и помочь вам справиться с диагнозом и лечением.

лимфаденопатия — рост лимфатических узлов;
пункция костного мозга и его гистологическое исследование на наличие атипичных лимфоцитов;